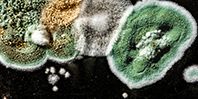

«Во-первых, бывают случаи, когда организм не очень здоров, тогда он может заболеть, потому что целый ряд грибов могут быть патогенными, болезнетворными для человека. Во-вторых, целый ряд веществ, которые грибы плесени выделяют в процессе своей жизнедеятельности, могут быть для человека токсичными и вызывать те или иные последствия — отравления, осложнения на почки, печень.
Сама по себе спора — это маленькая органическая частица. Попадая на слизистую оболочку, на кожные покровы, она может вызывать аллергическую реакцию. Когда грибов плесени немного, как правило, ничего страшного для организма нет. Если много, это может привести к аллергии. Кроме того, это может усугубить хронические заболевания.
Бывают случаи, когда иммунная система работает плохо, организм ослаблен. Это касается, в первую очередь, людей в постоперационный период, пожилых людей и людей с серьезными хроническими заболеваниями, людей, у которых иммунодефицит. При этом важную защитную роль играют полезные бактерии человека — они выступают как конкуренты грибной и прочей патогенной флоры», — говорит Дьяков.